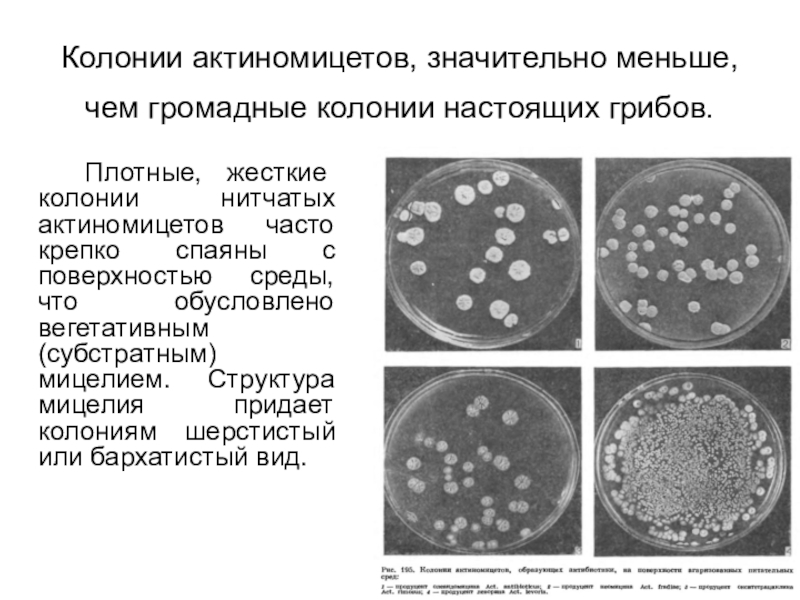

Разделы презентаций
- Разное
- Английский язык
- Астрономия
- Алгебра
- Биология
- География
- Геометрия
- Детские презентации
- Информатика
- История
- Литература
- Математика
- Медицина
- Менеджмент
- Музыка
- МХК
- Немецкий язык
- ОБЖ
- Обществознание
- Окружающий мир
- Педагогика
- Русский язык
- Технология
- Физика
- Философия
- Химия
- Шаблоны, картинки для презентаций
- Экология
- Экономика
- Юриспруденция
Актиномицеты
Содержание
- 1. Актиномицеты
- 2. Есть ли царство «грибы»?Мицелиальные прокариоты, которых раньше считали грибами и называли актиномицетами
- 3. Актиномицеты – это не грибы, а бактерии!
- 4. Actinobacteria – крупнейший тип домена Bacteria (один из 18). Важнейшие роды:StreptomycesCorynebacterium,Mycobacterium,Nocardia,Frankia,BifidobacteriumВажнейшие отряды:Actinomycetales,Bifidobacteriales
- 5. Впервые термин «лучистые грибы» - актиномицеты, был
- 6. Больше всего актиномицетов в почве.Распространены повсеместно как
- 7. Актиномицеты в почвеВ почве доминируют представители рода
- 8. ПрименениеДают около 2/3 используемых человеком антибиотиков, а также противораковые, противогельминтные, противогрибковые и др. вещества для медицины.
- 9. Сходство с грибамиМногие актиномицеты имеют мицелиальную жизненную
- 10. Многие актиномицеты образуют споры в специальных местах
- 11. Споры актиномицетов могут быть помещены в спорангии.
- 12. Различные типы споровых цепочек актиномицетов
- 13. Дифференциация мицелияПроявляется в делении на первичный (субстратный)
- 14. Вегетативный и спороносный мицелииКонидииСпорангии
- 15. Жизненный цикл спорулирующих актиномицетовХромосомная сегрегация и образование
- 16. Незрелую форму септального кольца называют Z-кольцом, по
- 17. Представители рода Oerskovia могут образовывать подвижные палочки при фрагментации гифов (только субстратные гифы).
- 18. На искусственных питательных средах актиномицеты образуют круглые,
- 19. Колонии актиномицетов, значительно меньше, чем громадные колонии
- 20. «The life cycle of the multicellular mycelial
- 21. Многоклеточнй представитель актиномицетов
- 22. Мокрота человека при актиномикозе лёгких
- 23. Актиномицет салиноспора на дне океана
- 24. Жук-лубоед Dendroctonus frontalis – вредитель сосны Место, где
- 25. Сельскохозяйственной деятельности жука мешает другой гриб — Ophiostoma,
- 26. Участок грибной плантации жука лубоеда.Видны тонкие нити
- 27. Ключевая роль – массвовая азотфиксация (хорошо описаны
- 28. Симбиотические азотфиксирующие актиномицеты из рода Frankia
- 29. Слайд 29
- 30. Слайд 30
- 31. Слайд 31
- 32. Слайд 32
- 33. Слайд 33
- 34. Внутреннее строение утолщений
- 35. Стрептомицеты – род актиномицетов, образующих споры в виде стрептококков
- 36. Слайд 36
- 37. Стрептомицеты – основной источник современных антибиотиковСтрептомици́н —
- 38. СтрептомицинЗельман Абрахам Ваксман (1888-1973)
- 39. Все ли лишайники образуются грибами?Актинолишайники встречаются на известковых породахАктинолишайники образованы актиномицетами и зелёными водорослями
- 40. Альгобактериальные ценозы в местах первичного образования почвыАктиномицетный
- 41. Актиномицеты относятся к: а) грибам; б) цианобактериям;
- 42. Представители актиномицетов НЕ способны осуществлять следующие процессы:
- 43. К одному царству относятся: А. лишайник, сфагнум, кукушкин
- 44. Возбудитель данной болезни может расти в аэробных
- 45. Антибиотики природного происхождения чаще всего продуцируются: а)
- 46. На рисунке изображены фотографии почвенных микроорганизмов. Рассмотрите
- 47. ЗАДАНИЯ теоретического тура заключительного этапа XXXI Всероссийской
- 48. Темы для научно-исследовательской деятельности школьниковВыявление стрептомицетов и
- 49. Скачать презентанцию
Слайды и текст этой презентации
Слайд 2Есть ли царство «грибы»?
Мицелиальные прокариоты, которых раньше считали грибами и
называли актиномицетами
Слайд 3Актиномицеты – это не грибы, а бактерии!
Актиномицеты - Actinomycetes
(от греч. actis - луч, туке -гриб) - грамположительные бактерии,
образующие подобие мицелия.Слайд 4Actinobacteria – крупнейший тип домена Bacteria (один из 18).
Важнейшие
роды:
Streptomyces
Corynebacterium,
Mycobacterium,
Nocardia,
Frankia,
Bifidobacterium
Важнейшие отряды:
Actinomycetales,
Bifidobacteriales
Слайд 5Впервые термин «лучистые грибы» - актиномицеты, был предложен Хартцем в
1878 г. для обозначения этих микроорганизмов. Это описательное название относится
к радиальному расположению нитей актиномицетов.Слайд 6Больше всего актиномицетов в почве.
Распространены повсеместно как на суше, так
и в водной среде. В поверхностном слое почвы их плотность
составляет 106-109 клеток на грамм. Попадаются также на глубине 2 м.Участвуют в образовании гумуса.
Являются важнейшими фиксаторами азота.
Их выделяют из молока, сыра, овощей, фруктов, живых и мертвых растений и т. п.
Вызывают ряд болезней животных и растений.
Слайд 7Актиномицеты в почве
В почве доминируют представители рода Streptomyces (95% всех
видов почвенных актиномицетов).
В почве соствляют 20% микробной флоры весной и
более 30% осенью.Слайд 8Применение
Дают около 2/3 используемых человеком антибиотиков, а также противораковые, противогельминтные,
противогрибковые и др. вещества для медицины.
Слайд 9Сходство с грибами
Многие актиномицеты имеют мицелиальную жизненную форму и подвергаются
сложной морфологической дифференциации.
Многие актинобактерии размножаются спорами.
Большое осмотическое давление, придающее
клеткам тургор. Поэтому клетка снаружи покрыта гидрофобной (гидрофобные белки) нерастягивающейся оболочкойСлайд 10 Многие актиномицеты образуют споры в специальных местах - спорангиях. Споры
круглые или продолговатые, бесцветные, формируются на ветвях воздушного мицелия. Гифы
очень тонкие 0,5 - 0,8 мкм.Слайд 13Дифференциация мицелия
Проявляется в делении на первичный (субстратный) и вторичный (воздушный)
мицелий.
Воздушный толще, его оболочка гидрофобна, содержит больше ДНК и
ферментов, на поверхности его клеток имеются различные структуры (палочковидные, фиблиллы). Вегетативный мицелий сильнее ветвится.
Слайд 15Жизненный цикл спорулирующих актиномицетов
Хромосомная
сегрегация и
образование септ
Созревание спор
Распространение
спор
Свободная
спора
Синтез
антибиотиков
Формирование репродуктивных воздушных гифов при недостатке питания.
Субстратные гифы лизируются, давая
дополнительное питание воздушным гифамВоздушные
гифы
Субстратный мицелий
Прорастание
споры
Рост удлинением гифов!
Слайд 16Незрелую форму септального кольца называют Z-кольцом, по имени белка FtsZ,
который играет ключевую роль в его формировании.
Белок FtsZ — прокариотический
гомолог тубулина с похожей третичной структурой. Это позволяет предполагать, что ассоциация FtsZ в Z-кольцо может напоминать сборку микротрубочек эукариот. Деление гиф с образованием спор
Слайд 17Представители рода Oerskovia могут образовывать подвижные палочки при фрагментации гифов
(только субстратные гифы).
Слайд 18На искусственных питательных средах актиномицеты образуют круглые, плотные, белоснежно -
мучнистые колонии.
Колонии многих видов часто окрашены в яркие
цвета: красный, оранжевый, желтый, встречаются серо - белые или с кремовым оттенком. Слайд 19Колонии актиномицетов, значительно меньше, чем громадные колонии настоящих грибов.
Плотные, жесткие колонии нитчатых актиномицетов часто крепко спаяны с
поверхностью среды, что обусловлено вегетативным (субстратным) мицелием. Структура мицелия придает колониям шерстистый или бархатистый вид.Слайд 20 «The life cycle of the multicellular mycelial Streptomyces starts with
the germination of a spore that grows out to form
vegetative hyphae, after which a process of hyphal growth and branching results in an intricately branched vegetative mycelium»Из обзорной статьи Jacquard C. et al.
«Taxonomy, Physiology, and Natural Products of Actinobacteria» // Microbiology and molecular biology reviews: MMBR · November 2015.
https://www.researchgate.net/publication/284716361_Taxonomy_Physiology_and_Natural_Products_of_Actinobacteria
Слайд 24Жук-лубоед Dendroctonus frontalis – вредитель сосны
Место, где находится микангий — полость
для хранения симбиотических грибов и бактерий.
Слайд 25Сельскохозяйственной деятельности жука мешает другой гриб — Ophiostoma, который не годится
в пищу личинкам и играет на жучиных плантациях роль агрессивного сорняка.
Гриб-сорняк действует не в одиночку, у него тоже есть покровители-симбионты — маленькие клещи, которые перебираются с одного дерева на другое, прицепившись к жуку-лубоеду.Слайд 26Участок грибной плантации жука лубоеда.
Видны тонкие нити актинобактерий (показаны тонкими
стрелками), переплетенные с более толстыми гифами гриба Entomocorticium (толстая стрелка). Длина
масштабной линейки — 10 мкм.Слайд 27Ключевая роль – массвовая азотфиксация (хорошо описаны представители рода Frankia,
что важно для берез, облепихи, ольхи и др.)
Утолщения на корнях
– чем-то похожи на клубеньки
На биологических экскурсиях можно отметить этот факт
Слайд 37Стрептомицеты – основной источник современных антибиотиков
Стрептомици́н — исторически первый антибиотик
группы аминогликозидов и первый, оказавшийся активным против туберкулёза и чумы.
Был открыт вторым после пенициллина Зельманом Ваксманом, за что он получил Нобелевскую премию в 1952 году.
Слайд 39Все ли лишайники образуются грибами?
Актинолишайники встречаются на известковых породах
Актинолишайники образованы
актиномицетами и зелёными водорослями
Слайд 40Альгобактериальные ценозы в местах первичного образования почвы
Актиномицетный мицелий окружает клетки
водорослей в водорослевых ценозах на выходах карбонатных пород
Слайд 41Актиномицеты относятся к:
а) грибам;
б) цианобактериям;
в) микоплазмам;
г)
бактериям.
Муниципальный этап XXXIII Всероссийской олимпиады школьников по биологии 2016-2017 учебный
год Алтайский край 11 класс+
Слайд 42Представители актиномицетов НЕ способны осуществлять следующие процессы:
а) гидролиз хитина;
б) азотфиксацию;
в) аноксигенный фотосинтез;
г) образование пигментов.
ЗАДАНИЯ теоретического тура
заключительного этапа XXXI Всероссийской олимпиады школьников по биологии. 2014-15 уч. год. 10-11 классы +
Слайд 43К одному царству относятся:
А. лишайник, сфагнум, кукушкин лён
Б. дрожжи,
аскарида, росянка
В. росянка, сосна, сфагнум
Г. актиномицеты, дрожжи, трутовик
ЗАДАНИЯ
теоретического тура заключительного этапа XXXI Всероссийской олимпиады школьников по биологии. 2014-15 уч. год. 10-11 классы +
Слайд 44Возбудитель данной болезни может расти в аэробных условиях:
1) ботулизм;
2) столбняк;
3) актиномикоз;
4) газовая гангрена;
5) дизентерия.
+
+
Ботулизм,
столбнк и газовая гангрена вызываются бактериями рода Clostridium, которые являются облигатными анаэробамиСлайд 45Антибиотики природного происхождения чаще всего продуцируются:
а) дрожжами;
б) аскомицетами;
в) актиномицетами;
г) одноклеточными водорослями.
+
Актиномицеты являются активными продуцентами антибиотиков,
образуя до половины известных науке, например, стрептомицин, эритромицин, тетрациклин.МУНИЦИПАЛЬНЫЙ ЭТАП ВСЕРОССИЙСКОЙ ОЛИМПИАДЫ ШКОЛЬНИКОВ В 2016/2017 УЧ.Г. ПО БИОЛОГИИ
Слайд 46На рисунке изображены фотографии почвенных микроорганизмов. Рассмотрите их внимательно и
выберите тот, на котором изображен актиномицет.
Всероссийская олимпиада школьников по биологии
в Санкт-Петербурге 2017/2018 учебный год. Районный этапСлайд 47ЗАДАНИЯ теоретического тура заключительного этапа XXXI Всероссийской олимпиады школьников по
биологии. 2014-15 уч. год. 10-11 классы
Самый известный из антибиотиков,
получаемых из актиномицетов, мицетин.Слайд 48Темы для научно-исследовательской деятельности школьников
Выявление стрептомицетов и других микроорганизмов, секретирующих
антибиотики.
Выявление (симбиотических) стрептомицетов, обитающих в древесине.
Выявление азотфиксирующих симбиотических стрептомицетов.
Поиск и
сбор коллекции природных азотфиксирующих образований на клубеньках.Микроскопическое изучение стрептомицетов, слизевых бактерий, слизевиков и настоящих грибов.